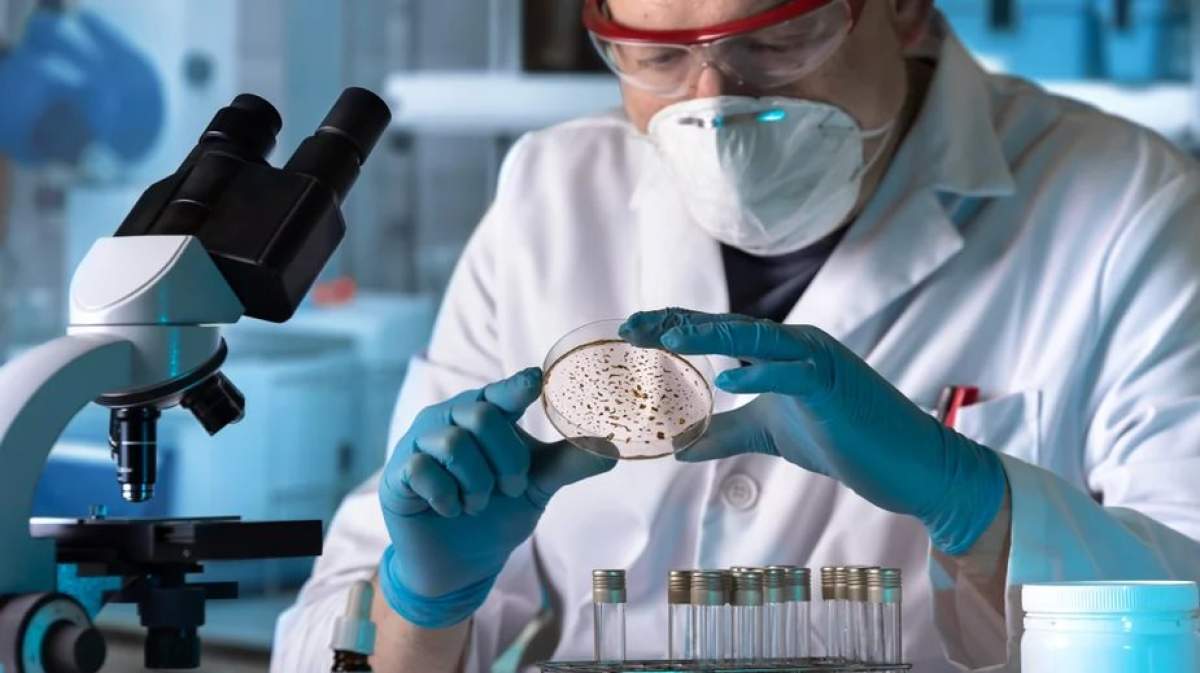

„Virusul poate să se transmită de pe haine”. Doctorul Marius Geantă, anunț despre variola maimuței
De Georgiana Prodan.
Publicat pe 26.05.2022 la 10:06
Actualizat pe 26.05.2022 la 10:06
Organizația Mondială a Sănătății a transmis că multe cazuri au fost înregistrate la persoane identificate ca homosexuali, bisexuali, deoarece virusul se răspândește prin contact apropiat. ȘI specialistul Marius Geantă a făcut mai multe declarații despre variola maimuței, boala care a revenit în zilele noastre, fără ca medicii să știe motivul.
- Care sunt principalele simptome ale acestei boli
- Cât de repede se transmite afecțiunea
- Anunțul specialistului Marius Geantă
Germania a raportat vineri primul caz de virus, devenind cea mai recentă țară europeană care a identificat un focar, printre Regatul Unit, Spania, Portugalia, Franța, Italia și Suedia. Așadar, în prezent, medicii din toată lumea sunt în alertă.
Doctorul Marius Geantă, anunț despre variola maimuței
Experții încearcă să determine cauza principală a creșterii cazurilor de infectare cu variola maimuței. Virusul a fost detectat pentru prima dată la maimuțele captive, în 1958. Primul caz uman a fost înregistrat în anul 1970.
De atunci, au fost raportate cazuri sporadice în 10 țări africane, inclusiv Nigeria, care în 2017 a cunoscut cel mai mare focar documentat, cu 172 de cazuri suspecte și 61 de cazuri confirmate. Virusul poate pătrunde în organism foarte ușor.
Doctorul Marius Geantă, președintele Centrului pentru Inovație în Medicină, a făcut un anunț de ultimă oră despre această afecțiune. Specialistul a explicat că variola maimuței se ia chiar și de pe haine.
Care sunt principalele simptome ale acestei boli
Așadar, această afecțiune se ia foarte ușor și prin căile respiratorii sau prin ochi, nas și gură.
„Virusul poate să se transmită de pe haine. Din acest motiv nu trebuie să stigmatizăm. Poate persoana infectată nu se duce la medic și nici nu anunță alți membri ai familiei din diverse motive. Este posibil ca o persoană să ia hainele pe care le poartă cel infectat și să le ducă la baie, de exemplu. Sau cineva poate să poarte hainele unei persoane infectate”, a declarat Marius Geantă, potrivit Ziare.com.
De asemenea, în spital, persoanele care schimbă lenjeriile paturilor în care stau bolnavii se pot infecta. Transmiterea de la animal la om poate avea loc prin mușcătură sau zgârietură. Variola maimuței nu este în general considerată o boală cu transmitere sexuală, deși poate fi transmisă în timpul actului sexual.
Simptomele inițiale ale variolei maimuței includ febră, dureri de cap, dureri musculare, umflături și dureri de spate.